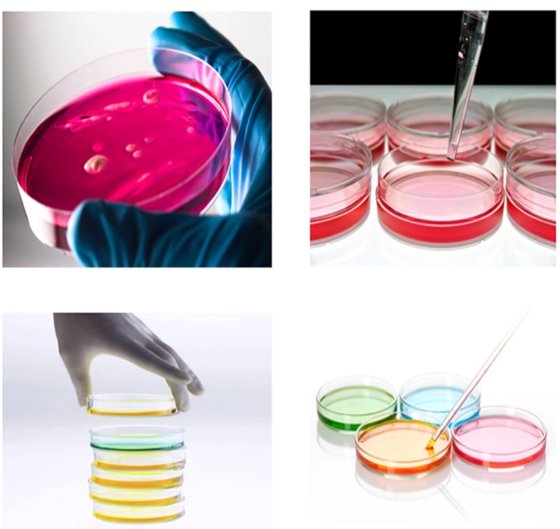
实验室耗材 培养皿

新 实验室耗材 培养皿 在 青岛市, 山东省, 中国
新
Doubleclick to zoom in
请联系卖家咨询
更多照片和设备细节。
规格参数
- 新旧状况
- 新
- Classification
- Petri Dish
- Brand name
- HIPROVE
- Model number
- 90*15mm
- Place of origin
- Shandong, China (Mainland)
- 分类
- 实验室耗材
- 产品编号
- 70786275
描述
5) the Petri dish has a moderately tight lid
Product model
Material
Qty / bag
Qty / ctn
35 x 15 mm Petri dish
PS
20
2600
60 x 15 mm Petri dish
PS
26
1040
65 x 15 mm Petri dish
(grid numbers)
PS
20
1000
70 x 15 mm Petri dish
PS
20
700
75 x 15 mm Petri dish
(ear)
PS
10
360
90 x 15 mm Petri dish
PS
10
500
90 x 15 mm Petri dish
(two lattice)
PS
10
500
90 x 15 mm Petri dish
(three lattice)
PS
10
500
90 x 20 mm Petri dish
PS
15
375
150 x 15 mm Petri dish
PS
10
180